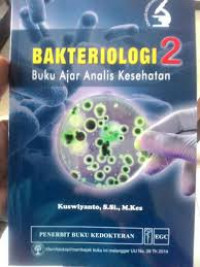
Bakteriologi 2

Text
Bakteriologi 2
Tidak Tersedia Deskripsi
Ketersediaan
| P0508S | 500 KUS b | IPA fisika,kimia,biologi (500) | Tersedia |
Informasi Detail
- Judul Seri
-
-
- No. Panggil
-
500 KUS b
- Penerbit
- Jakarta : EGC., 2018
- Deskripsi Fisik
-
x, 130 hlm.; 24 cm
- Bahasa
-
Indonesia
- ISBN/ISSN
-
978-979-044-713-4
- Klasifikasi
-
500 KUS b
- Tipe Isi
-
text
- Tipe Media
-
-
- Tipe Pembawa
-
-
- Edisi
-
-
- Subjek
- Info Detail Spesifik
-
-
- Pernyataan Tanggungjawab
-
-
Versi lain/terkait
Tidak tersedia versi lain
Lampiran Berkas
Komentar
Anda harus login sebelum memberikan komentar
 Karya Umum
Karya Umum  Filsafat
Filsafat  Agama
Agama  Ilmu-ilmu Sosial
Ilmu-ilmu Sosial  Bahasa
Bahasa  Ilmu-ilmu Murni
Ilmu-ilmu Murni  Ilmu-ilmu Terapan
Ilmu-ilmu Terapan  Kesenian, Hiburan, dan Olahraga
Kesenian, Hiburan, dan Olahraga  Kesusastraan
Kesusastraan  Geografi dan Sejarah
Geografi dan Sejarah